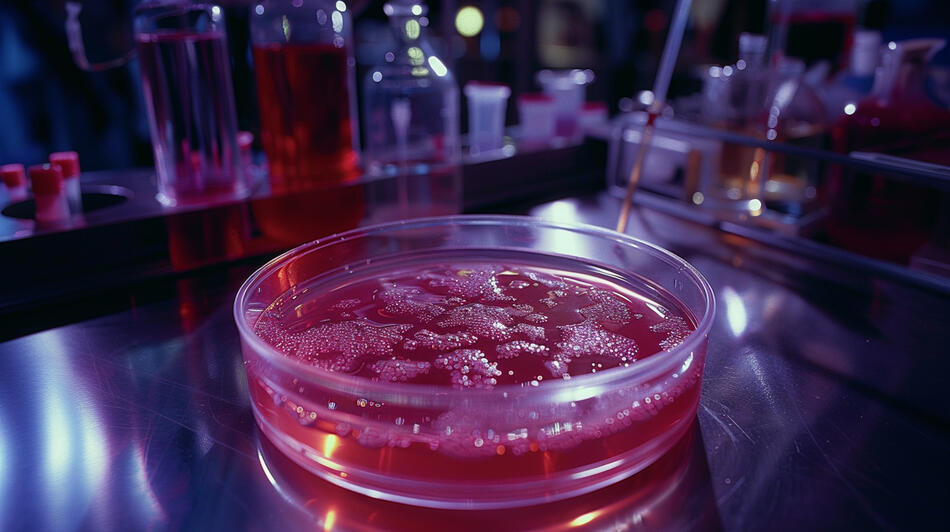

Showreel 1
Showreel 2
Trusted By

Burger King

Mediawan

Klutch Sports Group

Character.ai

Blumhouse Productions

Sandwatch

Dreamflare
ORIGINAL SOUNDTRACKS - NOW AVAILABLE
...

Solo Twin Studios is a premier AI video production studio co-founded by Guillaume Hurbault and Dale Williams (aka The Reel Robot), renowned as two of the world's leading AI filmmakers.Our pioneering work in AI-driven films has earned numerous festival accolades, captivated audiences globally with millions of views across social media, and garnered international exhibitions.We are storytellers, leveraging AI tools to create breathtaking films much more efficiently. The studio sources the best AI talent, and collaborates closely with filmmakers to ensure incredible stories are told with quick turnaround times.Solo Twin has produced 19 original series, and has been behind high profile advertisements, music videos and more.

Guillaume Hurbault

Dale Williams
CONTACT US: [email protected]
SOLO TWIN STUDIOS INC. | VANCOUVER, CANADA
CORPORATION NUMBER 1612157-8